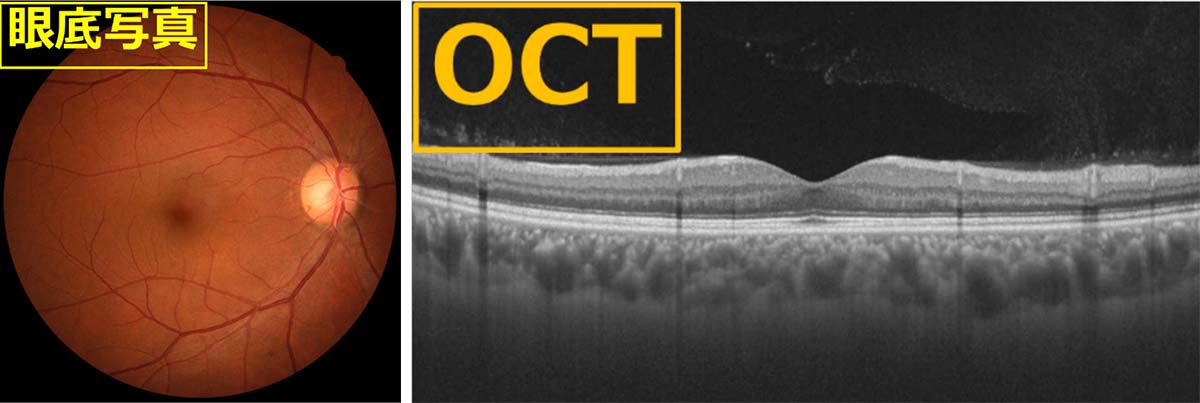
加齢黄斑変性の原因・治療方法｜茨城県水戸市の小沢眼科内科病院

加齢黄斑変性 加齢黄斑変性症 | 診療内容 | 医療法人 慶心会 なかやま眼科クリニック
(4114件)
Pontaパス特典
サンキュー配送
6000円(税込)
60ポイント(1%)
Pontaパス会員ならさらに+1%ポイント還元!
送料
(
)
4102
配送情報
お届け予定日:2026.05.04 21:45までにお届け
※一部地域・離島につきましては、表示のお届け予定日期間内にお届けできない場合があります。
ロットナンバー
14104102221
お買い物の前にチェック!

Pontaパス会員なら
ポイント+1%
ポイント+1%
商品説明





「加齢黄斑変性」吉村 長久定価: 15750円#吉村長久 #吉村_長久 #本 #自然/医療・薬学・健康記名部分をマジックで消しています。少し書き込みがありました。いかがでしょうか。
| カテゴリー: | 本・雑誌・漫画>>>本>>>健康・医学 |
|---|---|
| 商品の状態: | やや傷や汚れあり","目につく傷や汚れがある |
| 配送料の負担: | 送料込み(出品者負担) |
| 配送の方法: | 佐川急便/日本郵便 |
| 発送元の地域: | 未定 |
| 発送までの日数: | 2~3日で発送 |
レビュー
商品の評価:




 4.8点(4114件)
4.8点(4114件)
- ruka0801
- そろそろ一歳になる娘用に購入しました。 楽しそうに遊んでくれて良かったです。
- トッコ1026
- 姪っ子へのプレゼント。 子供がお野菜・果物シリーズが好きなので、こちらも楽しめるのでは?と思い購入しました。 中身は分かりませんが、温かみのあるイラストがほっこりします。
- ミーさん029
- 楽しかった♪ 読む部分は少ないけれど、絵を見るのがとっても楽しい☆ 縦に開いて見るから 迫力があっていい☆ 作者はいないいないばぁのオープニング担当した人なんだって-(*^^*)♪
- ひろリン1212
- 思ったより、しっかりした作りで喜んでました。ただ、音を最大にしても小さめなのでもう少し大きかったらいいなぁとおもいました。
- ななみくままさん
- お友達の子供ちゃんにプレゼントとして購入しました。 ゴーオンジャー大好きなので喜んでくれました。
- r*
- 子供と何度読んでもほのぼのしてしまう絵本です。 あかたろうが、お母さんをさがしている姿に私をさがす幼い頃の息子を垣間見たり・・・一人思い出しては懐かしく切なくなったり・・年かな笑。。 親子共々大好きな一冊です。
- ☆☆ミィ★★
- いないいないばあっ!大好きな1歳の娘ちゃん用に。。 毎日みてますw
- 加藤ますく
- 3歳半の息子に購入。年齢的に遅いかな…とも思いましたが、レビュー評価が高くて気になり、本屋で探してもなかったのでこちらで購入しました。結果は毎日見てくれているので、買ってよかった絵本のひとつです。仕掛け絵本は色々と見てきましたが、こちらはより一層色合いが鮮やかで、お値段は高めですが大人も癒される絵本かと思います。
- s.reo
- 6ヶ月のときに購入。 あまり面白くなかったのか、興味を示してくれませんでしたが 8ヶ月になって見せてみると、「もこ」と少しだけ盛り上がる部分に釘付けになりました。 A4サイズと少し大き目の本なので、ちょっとめくりにくいのが難点です。 あと価格も高いのが・・・汗
- yacco0721
- 3-6歳と書かれていますが小学生にもオススメです! 以前小1の子供に頂いて、とてもよかったので今回こちらを購入し、小学校に寄付しましたが先生たちからもとても好評でした。 「年齢表記ありましたが小学生にもピッタリですね!」と先生たちも私と全く同じ反応でした(^^)笑 生徒さん達も興味津々でみんなで読んでいたりクイズをだしたりと楽しんでくれていたそうです。 イラストも可愛らしくて、いろんな地域の食べ物なども鮮やかに書かれており、非常に素敵な一冊です。 中学年、高学年になってもきっと社会の授業などで役立つだろうし、おそらく子供達が中学生になるまで活躍するのでは、と思います(^^)
- ミンキーモモカ
- 造りが丈夫で、 「大好きなアンパンマンの本を持ち歩きたい」という子供の願望を満たしてくれる商品だと思います。 実に理にかなった商品だと思います。
- NARU0322
- 届いた商品はとてもきれいでした。1歳の娘の誕生日に購入したものですが、私も小さい頃持っていたシリーズの絵本なので、嬉しくなりました。キャラクターごとの単本の内容とはちょっと違うようですが、絵もかわいくて満足です。
- あられ4340
- 書店で売り切れになっていたのでこちらを利用しましたが、注文の翌日に届き感激しました。 このシリーズの本に大人がハマり、少しずつ揃えていこうと計画中です。機会があればまた利用します。
- asami1988108
- ほのぼのとした感じのかわいい絵です。1歳になったばかりの子どもはあまり興味を持ちませんでした。少し,大きくなってから見せたら喜んでくれると思います。
すべて見る
お店の情報
7,367
連絡・応対
4.3
配送スピード
4.3
梱包
4.3